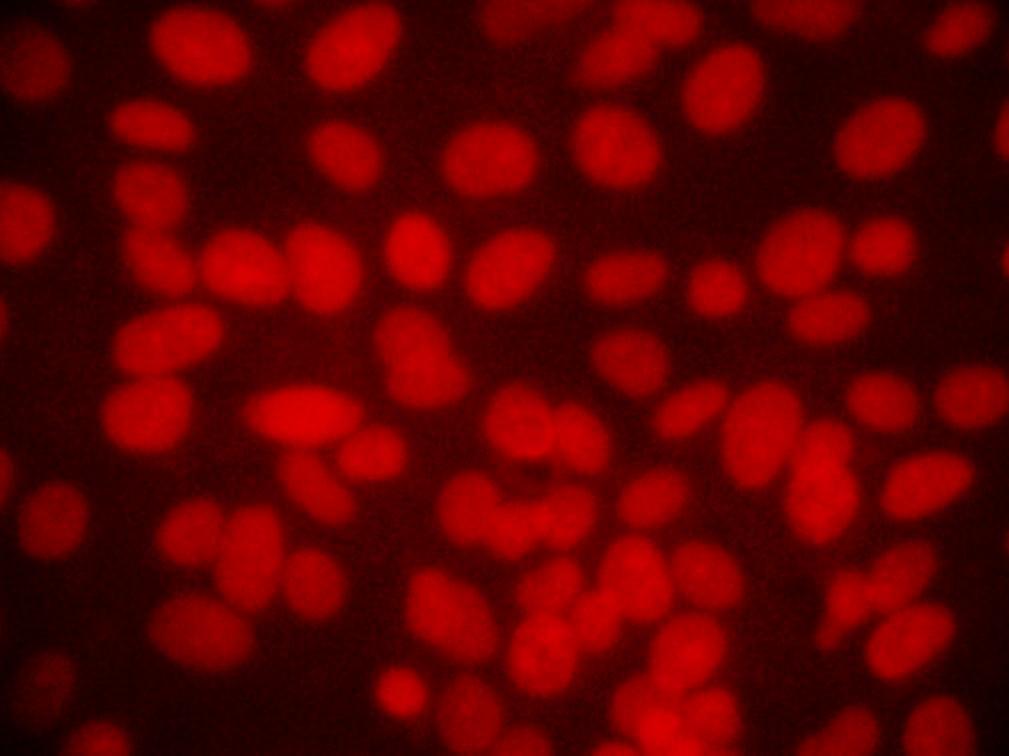

1Department of Biotechnology, Research scholar, Sathyabama University, Sholinganallur 600119, Chennai, 2Department of Biotechnology,K. S. R. College of Technology,Tiruchengode, 3Department of Biotechnology,Hindustan college of arts and science,Kelambakkam, Chennai, 4School of life & environmantal science, Deakin University,Australia.
Email: lksamy2004@yahoo.com
Received: 12 Jun 2014 Revised and Accepted: 19 Jul 2014
ABSTRACT
Objective: To study the cytotoxic & apoptotic efficacy of synthesized silver nanoparticles from I. aspalathoids against Hep3B cell line.
Methods: Hep3B cell line was purchased from American type culture collection (NCCS, Pune). The cells were treated with synthesized silver nanoparticles from I. aspalathoids for 24 & 48 hrs. Cell Viability was evaluated by MTT assay and DNA fragmentation assay.
Results: The IC50 (half maximal inhibitory concentration) value of the AgNPs on Hep3B cells was calculated to be194.65ng/ml. The treated cells were compared to the control group with respect to morphology. The mechanism of cell death was studied through ethidium bromide/acridine orange. The live untreated cells had well organized chromatin structures, whereas the treated cells had fragmented or condensed chromatin consisting of apoptotic nuclei. Therefore, the nuclear staining experiment shows that apoptosis started in 48h after addition of AgNPs to the culture medium.
Conclusion: The study demonstrated the possible of the use of biologically synthesized silver nanoparticles from I. aspalathoids as an effective drug against cancer.
Keywords: I. aspalathoids, Hep3B cell line, AgNPs, Cell viability, Cancer.
INTRODUCTION
Nanoparticles are viewed as fundamental building block of nanotechnology [1.] The nanoparticles synthesized from metals have received considerable attention in recent years because of their unique properties and potential applications in catalysis, photonics, optoelectronics, biological tagging and pharmaceutical applications. In chemical synthesis method presence of some toxic chemical which are absorbed on the surface will have adverse effect in the medical applications [2]. So, now a day biosynthesis of nanoparticles is used by most of researchers to overcome the above problems [3]. Silver (Ag), as a noble metal, has potential applications in medicine due to its unique properties [4]. AgNPs have several characteristics that make it currently among the most widely used nanoparticle in science. The green synthesis is more advantageous over chemical and physical method as it is cost effective and environment friendly [5]. Nanoparticles green synthesis is not time consuming compared to other biological processes [6]. Synthesis of SNPs using different medicinal plants for pharmaceutical and biological applications have been reported [7]. The use of environment benign materials like plant leaf extracts, bacteria, fungi and enzyme for the synthesis of silver nanoparticles offers biomedical applications such as drug delivery, cancer treatment. Cancer is an abnormal type of tissue growth in which the cells exhibit an uncontrolled division [8]. There is increasing demands for anticancer therapy [9]. Invitro cytotoxicity testing procedures reduces the use of laboratory animals [10] and hence use of cultured tissues and cells have increased [11]. The present study was carried out to verify the possible cytotoxic action of AgNPs synthesized using I. aspalathoids on HEp3B cells, evaluating morphology and the number of viable cells after incubation with the plant extract.
Experimental
MATERIALS AND METHODS
Cell culture
Hep3B cell line American type culture collection (NCCS, Pune) was purchased. The cells were grown in T75 culture flask containing MEM supplemented with 10% FBS. Upon reaching confluence, the cells were detached using Trypsin-EDTA solution.
Passaging of cells
Upon reaching confluence hepatocellular carcinoma cell line Hep3B were passaged as follows. The medium from the culture flask was aspirated. The flask was rinsed with 2 ml of PBS and aspirated again quickly. 1.5-ml of tryspin solution was added and incubated at 37oC about 2 minutes until cells started detaching. As soon as the cells were detached using a transfer pipette, the trypsinized medium containing cells was centrifuged at 100 rpm for 5 min. The medium was carefully aspirated off and care was taken not to put the pipette tip in the bottom of the tube, where the cells were pelleted. The cells were gently resuspended in the MEM medium with 10% FBS by pippetting up and down 5-8 times. From the cell suspension, a drop was placed on the edg of the cover slip of neubaurer hemocytometer. The drop was led to run under the cover slip by capillary action. Care was not taken not to force the liquid and the entry of air bubble was avoided. Then the cells from the E1, E2, E3, E4 and E5 squares were counted under microscope. The cells were then gently resuspended and transferred to sterile T culture flasks and the volume of medium upto 10 ml with growth medium per flask.
Cell proliferation assay
The proliferation of Hep3B cells was assessed by MTT assay [12]. Hep3B cells were plated in 24 well plates at a concentration of 5 x 104 cells/well 24 hours after plating; cells were washed twice with 500 μl of serum-free medium and starved by incubating the cells in serum-free medium for an hour at 37oC. After starvation, cells were treated with Nanoparticles of different concentrations for 24 hours.
At the end of treatment, the medium from control and Nanoparticles treated cells were discarded and 500μl of MTT containing MEM medium (0.5 mg/ml) was added to each well. The cells were then incubated for 4 h at 37oC in the CO2 incubator. The MTT containing medium was then discarded and the cells were washed with 1x PBS (1 ml). The crystals were then dissolved by adding 500μl of solubilization solution and this was mixed properly by pippeting up and down. Spectrophotometrical absorbance of the purple blue formazan dye was measured in microplate reader at 620 nm. The OD of each sample was then compared with the control OD and the graph was plotted.
Acridine orange/ethidium bromide (AO/EB) staining
The AO/EB staining was carried out [13]. Fluorescent dyes, ethidium bromide (100 μg/ml) and acridine orange (100 μg/ml) were added to the fixed cells and incubated for 10 min at room temperature in dark. Changes in the nuclei of cells within 15 min. after AO/EB staining were observed under a fluorescence microscope. Morphological criteria were used to evaluate cell injury. Cells containing normal nuclear chromatin exhibit green nuclear staining. Cells containing fragmented nuclear chromatin due to apoptosis exhibit Yellow to red nuclear staining.
Assessment of Nuclear morphology by propidium iodide staining
The propidium iodide staining was carried out [14]. Hep3B cells were plated at a density of 5 x 104 in 6 well plates containing sterile cover slips. They were allowed to grow at 37oC in a humidified CO2 incubator until they are 70-80% confluent. Then cells were treated with Nanoparticles for 2 different time points (24 h and 48 h). The culture medium was aspirated from each well and the cells were gently rinsed twice with PBS at room temperature, fixed in methanol: acetic acid (3:1 v/v) for 10 min and stained with 50 μg/ml propidium iodide for 20 min. Nuclear morphology of apoptotic cells with condensed/fragmented nuclei was examined under a fluorescent microscope and a least 1x103 cells were counted for assessing apoptotic cell death.
DNA agarose gel electrophoresis
DNA extraction and agarose gel electrophoresis were performed.1x106 cells were plated in 100 mM petri dishes with MEM containing 10% FBS. The cells were incubated for 24 h under 5% CO2 and 95% air at 37oC. The cells were treated with IC50concentrations of Nanoparticles. After 24 h, 48 h both treated and control cells were tryspsinized and combined with the cells in the medium centrifugation at 1500 rpm for 5 min, washed twice with PBS, the resulting pellet was resuspended in 0.25 ml of lysis buffer, transferred to a microfuge tube and incubated for one hour at 37oC. To this 4 μl proteinase K was added and the tubes then incubated at 50oC for 3 hr. To each tube, 0.5 ml of Phenol:chloroform:isoamlyalcohol (25:24:1) was added, mixed and centrifuged at 13,000 rpm for 30 min at 4oC to separate DNA containing upper aqueous phase. To the resulting aqueous phase, 2 volumes of ice cold absolute ethanol and 1/10 the volume of 3 M sodium acetate were added and kept at -20oC overnight to precipitate DNA. The DNA was pelleted by centrifuging at 13,000 rpm for 10 min at 4oC the supernatant was aspirated and the pellet was washed with 1 ml of 70% ethanol.
After repeating the above centrifugation step and removing the last traces of the supernatant fraction, the pellet was allowed to dry at room temperature for approximately 30 min and resuspended on 50 μl of TE buffer. The DNA was quantitated by UV-visible spectroscopy and 10 μg of DNA was electrophoresed in a 1.5% agarose gel containing ethidium bromide in a mini gel tank containing TBE buffer for 2 hr under 90 V. The gel was examined under UV light and photographed.
RESULTS AND DISCUSSION
The nanoparticles synthesized using the plant system have applications in the field of medicines, cancer treatment, drug delivery, commercial appliances and sensors. The in vitro cytotoxicity effects of silver nanoparticles were screened against cancer cell lines and viability of tumor cells was confirmed using MTT assay. Characterization of in vitro nanoparticles uptake and localization is intrinsically linked to cytotoxicological studies because uptake provides evidence of nanoparticle–cell interaction, wherein the delicate intracellular machinery is exposed to nanoparticles. Compared to in vivo studies, in vitro studies benefit from being faster, lower cost, allowing greater control, and minimizing ethical concerns by reducing the number of laboratory animals required for testing
Invitro cytotoxicity of silver nanoparticles synthesized from Indigofera aspalathoids was evaluated on Hep3B cell line. The potential effects of silver nanoparticles synthesized from Indigofera aspalathoids on proliferation and survival of Hep-3B cells, the cells were exposed to 0–1000 μg/ml of silver nanoparticles for 72 h. (Figure 1 and 2) show that silver nanoparticles induces cell death in a dose- dependent manner, as determined using MTT assay. The results shows that silver nanoparticles induces cell death significantly with an average IC50 value of 194.65 ±1.45. Thus, the results shows that the silver nanoparticles inhibits the proliferation of the cell. Silver nanoparticles had important anti angiogenic properties [15], so are attractive for study of their potential antitumor effects. The toxicity of nanosilver on oestoblast cancer cell lines results demonstrate a concentration-dependent toxicity with 3.42 μg/ml of IC50 suggest that the product is more toxic to cancerous cell comparing to other heavy metal ions [16].

Fig. 1: Shows the MTT assay

Fig. 2: Effect of AgNPs on Hep2 cell viability,graph shows the IC 50 value= 194.65 µg/ml
The morphological examinations of the Hep 3B cells were illustrated using phase contrast microscope. The control group cells showed a typical polygonal and cobblestone monolayer appearance (Figure 3a). Significant decrease of the number of Hep 3B cells treated with silver nanoparticles for 24 h (Figure 3b) was observed compared to the control group. Furthermore, the cell treated with silver nanoparticles for 48h began to have morphological changes; showing round-shaped cells poorly adhered to the culture flasks (Figure 3c).

Fig. 3a: Control cells of Hep 3B cell line

Fig. 3b: 24 hrs after treatment of Hep 3B cell line with IC50 concentration

Fig. 3c: 48 hrs after treatment of Hep 3B cell line with IC50 concentration
To better understand morphological change of Hep 3B cells after silver nanoparticles treatment, the cells were observed under acridine orange/ethidium bromide (AO/EB) double staining after treatment at different time points of silver nanoparticles. The figure shows. that the Silver Nanoparticles induced apoptosis after 24 and 48 hours incubation. Cells stained green represent viable cells (Figure 4a), whereas bright greenish yellow staining represented early apoptotic cells, and reddish or orange staining represents late apoptotic cells. As shown in (Figure 4b) Hep 3B cells after 24 hours treatment showed slight changes in cellular morphology, including chromatin condensation and fragmented nuclei. On the other hand, (Figure 4c) show higher number cells with increased chromatin condensation with increased fragmented nuclei thus it represents increase in the number of apoptotic cells after 48 hours of treatment.

Fig. 4a: Detection of Apoptosis Acridine orange/ Ethidium bromide Dual staining - Hep 3B cell line Control

Fig. 4b: 24 hrs after treatment of Hep 3B cell line with IC50 concentration

Fig. 4c: 48 hrs after treatment of Hep 3B cell line with IC50 concentration
Therefore, using the AO/EB staining procedure, the morphological features of a Hep 3Bcell line in apoptosis were time dependent, i. e., a stronger apoptosis signal was induced with increase in the time. The cytotoxic effects of SNPs, probably due to the fact that SNPs may interfere with the proper functioning of cellular proteins and induce subsequent changes in cellular chemistry [17.18] reported a significant cytotoxicity of AgNPs in BRL 3A rat liver cells.
The fluorescence micrograph of the control and Silver nanoparticles treated Hep3B cells assessed for nuclear morphology after staining with propidium iodide stain. The control untreated Hep3B cells (Figure 5a) shows clear nuclei. The highly condensed and fragmented nuclei that are the index of apoptosis were observed in silver nanoparticles treated cell at different time point 24 h and 48 h (Figure 5b and c). The apoptotic nuclei after treatment with silver nanoparticles found to be increased in a time dependent manner which was clearly revealed by nuclear condensation and fragmentation.
Fig. 5a: Detection of Apoptosis Using PI staining- Hep 3B cell line control

Fig. 5b: 24 hrs after treatment of Hep 3B cell line with IC50 concentration, arrows indicates the cells with fragmented nuclei

Fig. 5c: 48 hrs after treatment of Hep 3B cell line with IC50 concentration, arrows indicates the cells with fragmented nuclei
DNA fragmentation occurs in cells that produce intrinsic apoptosis activity when induced by a variety of agents. This cleavage produces ladders of DNA fragments that are the size of integer multiples of a nucleosome length (180–200 bp). As a biochemical hallmark of intrinsic apoptotic cell death, DNA fragmentation was used to determine whether the antiproliferative effect of silver nanoparticles on cells acts through apoptosis pathway. The treatment of Hep 3B cells treated at different time intervals (Lane 2–3; Figure 6) showed typical features of DNA laddering on an agarose gel, whereas untreated cells produced intact genomes (Lane 1; Figure 6). Therefore, the silver nanoparticles synthesized from Indigofera aspalathoids can induce nucleosomal DNA fragmentation of Hep3B cells. ROS plays an important role in triggering many cellular pathways which can lead to cellular death, including cytokine activation [19] and caspase activation [20]. They can also cause damage to the nuclear DNA by altering the chemical structure of the nucleotide bases and the deoxyribosyl backbone [21]. The cytotoxic effects of silver are the result of active physicochemical interaction of silver atoms with the functional groups of intracellular proteins, as well as with the nitrogen bases and phosphate groups in DNA.

Fig. 6: DNA fragmentation assay showing lane1: marker, lane2: control, lane3:24 hrs treatment, lane 4:48 hrs treatment
CONCLUSION
In the present study silver nanoparticles synthesized from I. aspalathoids have exhibited a significant cytotoxic effect on HEp 3B cell lines in vitro through induction of apoptosis and by inhibiting cell proliferation and angiogenesis. Further studies are needed in order to analyze the mechanism behind the effects observed and the effects of silver nanoparticles synthesized from I. aspalathoidon mammalian immune system. Our data suggest that silver nanoparticles synthesized from Indigofera aspalathoids can induce cytotoxic effects on Hep3B cells, inhibiting tumor succession and thereby effectively controlling disease progression without toxicity to normal cells and these agents an effective alternative in tumor and angiogenesis-related diseases.
CONFLICT OF INTERESTS
Declared None
REFERENCES